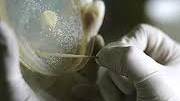
Gov Scientists Will Experiment With H7N9 in Bio-Weapons Labs

Gov Scientists Will Experiment With H7N9 in Bio-Weapons Labs
Source: occupycorporatism.com
Scientists are experimenting with the H7N9 bird flu virus in high-security laboratories with the accord of the US government.A review panel and excessive oversight is being promised to make sure that these “flu projects” are devoid of risk to the general public.
The probability of human-to-human transmission of the new strain of H7N9 is being analyzed while experts decry that there is no evidence of a pandemic.
James Rudge and Richard Coker of the London School of Hygiene and Tropical Medicine (HTM) declared that “the threat posed by H7N9 has by no means passed.”
So far, H7N9 has not successfully transmitted to humans with efficiency which means this virus is still a very low risk to humans.
Scientists are warning that this endeavor would pose more of a problem and there should be preparations made for a “worst-case scenario”.
The Department of Health and Human Service (DHHS) concluded that with the controls in place, the experiments on H7N9 were worth the risk.
[...]
Read the full article at: occupycorporatism.com